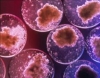

Tutti amano il caffè. C’è chi è legato alla tradizionale moka, chi, invece, è votato al monodose. Una cosa è certa: la ricerca costante del caffè perfetto, col consumatore italiano sempre più esigente, soprattutto, nel cercare di soddisfare i propri gusti tra le mura domestiche.
A supporto di questa tesi, i dati emersi da un’indagine svolta dal 15 al 22 Marzo 2021 tra consumatori appartenenti alla digital community BVA Doxa Roamler, relativi al consumo di caffè in casa. Analisi che evidenzia un mondo in piena evoluzione: il 57% degli intervistati utilizza il caffè monoporzionato, dato che supera il caffè confezionato macinato per la moka (56%) che così perde il primato in termini di consumo con un’ascesa sempre più rapida del caffè monodose. Se la mattina a casa c'è ancora la tradizione della moka forse per il suo innegabile “romanticismo” e il classico profumo che inonda la casa, in ufficio e per il “consumo fuori casa” il porzionato regna incontrastato grazie ai suoi vantaggi: qualità, praticità e affidabilità, cui vanno ad aggiungersi, in fatto di cialde, aspetti altrettanto importanti ed attuali. Come l’ecosostenibilità, ambito in cui la cialda spicca, rappresentando, rispetto ad altri metodi di preparazione, il più green e il mezzo più economico per ottenere un buon caffè, grazie all’assenza di plastica e metallo, che permette di contenere i costi.
Dalla stessa indagine emerge anche che a preferire cialde e capsule sono i 18-34enni, mentre il caffè in moka è scelto maggiormente dagli over 45.
Tra cialda e capsula, in materia di ecosostenibilità, non c’è sfida: la cialda, grazie al caffè pressato tra due veli di filtro carta risulta il sistema “green” per eccellenza. Non a caso, una volta esausta, si smaltisce nell’umido trasformandosi in compost riutilizzabile come fertilizzante naturale.
Corposo, denso e cremoso: questi gli attributi richiesti al “caffè al bancone”, che appartengono anche alla cialda. I motivi che li avvicinano sono vari. Per quanto riguarda il confezionamento della cialda, ad esempio, durante l’estrazione del caffè, non c’è contatto con materiali resistenti come plastica o alluminio, ma solo con il naturale filtro carta e ciò garantisce il gusto omogeneo tipico del “caffè del bar”.
Inoltre la maggior parte delle cialde in commercio sono Easy Serving Espresso, ovvero totalmente compatibili con diversi marchi e modelli di macchine, a differenza delle capsule dove i sistemi sono chiusi e di conseguenza vincolano il consumatore a utilizzare capsule che si adattano a specifiche macchinette per espresso. I vantaggi sono numerosi: il più importante riguarda la libertà di scelta. Il consumatore ha la possibilità di scegliere tra un’ampia varietà di gusti e cialde offerte da vari marchi, acquistare la macchina da caffè dell’azienda che preferisce e allo stesso tempo, sperimentare e diversificare.